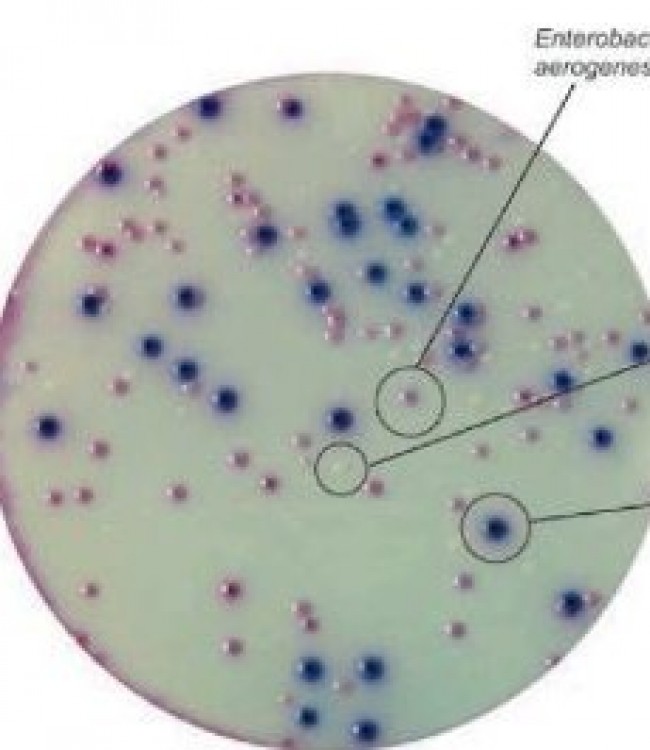

Chromogenic E. Coli / Koliform Agar
Chromogenic E.coli / Koliform Agar
Mikrobiyolojik analizlerde koliform grup bakteriler ve E. coli aranması ve sayılması için selektif katı besiyeri olarak kullanılır.
Koliform grup bakteriler için karakteristik olan B-D—galaçtosidase enzimi Salmon-GAL kromojenik substratını parçalayarak koliform bakterilerin pembemsi kırmızı koloni oluşturmasını sağlar.
Bileşimdeki X—Gluçuronide substratı ise E. coli için karakteristik olan
B-D-Gluouronidase enzimi tarafından parçalanır.
Boylece E. coli koliform bakteri olarak Salmon-GAL'i parçalaması yanında
X—Glucuronide substratını da parçalayarak diğer koliform bakterilerden koyu mavi-menekşe renkli koloni oluşturması ile ayrılır.
Besiyeri bileşimindeki triptofan varlığı doğrudan koloni üzerinde indol testi yapılmasına izin verir.
Gram negatıfler renksız kolonı oluştururlar.
Bunlardan bir kısmı B—D-Gluouronidase aktivitesi nedeni ile açık
mavi-turkuaz renkli koloniler meydana getirirler.